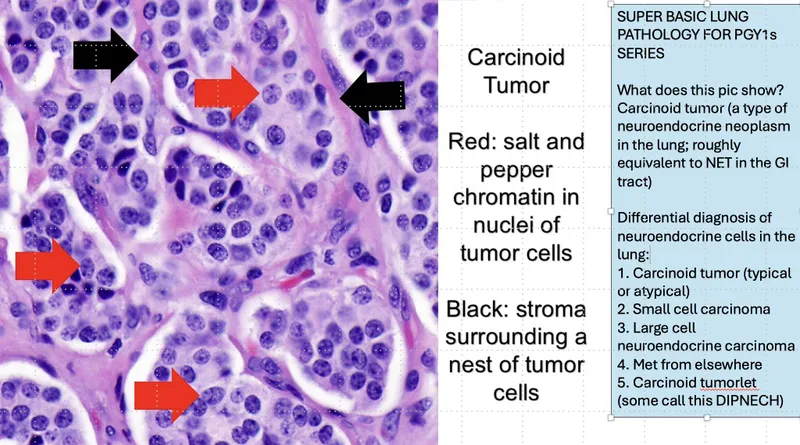
Carcinoid Tumor: Salt-and-Pepper Chromatin

NETs Overview - Tumor Genesis Gems
- Definition: Neoplasms from neuroendocrine (APUD) cells.
- Origin: Enterochromaffin (Kulchitsky) cells.
- Common Sites: GIT (commonest), pancreas, lung.
- Classification:
- Functional (hormone+) / Non-functional.
- WHO Grade (Ki-67/mitoses):
- G1: Ki-67 <3%, Mitoses <2/10HPF
- G2: Ki-67 3-20%, Mitoses 2-20/10HPF
- G3: Ki-67 >20%, Mitoses >20/10HPF
⭐ Midgut NETs with liver mets most often cause carcinoid syndrome (flushing, diarrhea, bronchospasm).
Carcinoid Syndrome - Crimson Tide Tales
- Pathophysiology: From vasoactive substances (serotonin, kallikrein, prostaglandins, histamine) from NETs, bypassing liver metabolism.
- Classic Triad: Episodic cutaneous flushing (crimson), secretory diarrhea, and bronchospasm.
- 📌 Mnemonic FDR: Flushing, Diarrhea, Right-sided heart lesions.
- Carcinoid Heart Disease: Right-sided valvular fibrosis causing Tricuspid Regurgitation (TR) and Pulmonary Stenosis (PS).
- Diagnosis: Elevated 24-hour urinary 5-hydroxyindoleacetic acid (5-HIAA), >25 mg/24h.
- Triggers: Alcohol, stress, anesthesia, certain foods (aged cheese, red wine).

⭐ Octreotide (somatostatin analog) is used for symptomatic treatment and can also help localize tumors via OctreoScan.
Pancreatic NETs - Pancreas's Peculiar Posse
| Tumor | Syndrome/Key Features | ↑Hormone |
|---|---|---|
| Insulinoma | 📌 Whipple's triad (hypoglycemia, neuroglycopenic sx, glucose relief); ↑C-peptide; ~90% benign. | Insulin |
| Gastrinoma | Zollinger-Ellison (ZES): refractory PUDs, diarrhea; Gastrin >1000 pg/mL, gastric pH <2; often malignant, MEN1 assoc. | Gastrin |
| VIPoma | WDHA/Verner-Morrison: Watery Diarrhea, Hypokalemia, Achlorhydria; "pancreatic cholera". | VIP |
| Glucagonoma | 4Ds: Dermatitis (necrolytic migratory erythema), Diabetes, DVT, Depression; weight loss. | Glucagon |
| Somatostatinoma | "Inhibitory" syndrome: Diabetes, cholelithiasis, steatorrhea, hypochlorhydria. | Somatostatin |
⭐ Octreotide scan (Somatostatin Receptor Scintigraphy, SRS) aids localization for most pNETs (gastrinoma, glucagonoma, VIPoma, somatostatinoma); insulinomas often require other localization studies due to variable receptor expression. Insulinomas are the most common pNET overall, but gastrinomas are most common in MEN1.
NET Diagnosis & Staging - Clue Cracking & Counts
- Biochemical Markers:
- Chromogranin A (CgA): General NET marker.
- Specific hormones (e.g., insulin, gastrin) if tumor is functional.
- Imaging Pathway:
- CT/MRI: Initial localization.
- Somatostatin Receptor Scintigraphy (SRS): Octreoscan.
- ⁶⁸Ga-DOTATATE PET/CT: Gold standard for SSTR imaging.
- Endoscopic Ultrasound (EUS): For pancreatic/GI NETs.
- Biopsy & Grading:
- Histology confirms diagnosis.
- Grading (Ki-67 index, mitotic rate): G1 (Ki-67 $\le$2%), G2 (Ki-67 3-20%), G3 (Ki-67 $>$20%).

⭐ ⁶⁸Ga-DOTATATE PET/CT offers superior sensitivity over Octreoscan for detecting SSTR-positive NETs and is crucial for staging and PRRT planning.
NET Management - Taming the Tiny Terrors
- Surgery: Primary curative option for localized disease. Resection of primary and, if feasible, metastases.
- Somatostatin Analogs (SSAs): Octreotide, Lanreotide.
- Control hormonal syndromes (e.g., carcinoid).
- Anti-proliferative in well-differentiated NETs.
- Peptide Receptor Radionuclide Therapy (PRRT):
- $^{177}$Lu-DOTATATE targets SSTR-positive tumors with radiation.
- Targeted Molecular Therapies:
- Everolimus (mTOR inhibitor) for advanced pNET, GI, lung NETs.
- Sunitinib (tyrosine kinase inhibitor) for advanced pNETs.
- Chemotherapy: Streptozocin, Temozolomide.
- Reserved for high-grade, aggressive, or rapidly progressive NETs, especially poorly differentiated neuroendocrine carcinomas (NECs) and some pNETs.

⭐ Peptide Receptor Radionuclide Therapy (PRRT) with $^{177}$Lu-DOTATATE has shown significant improvement in progression-free survival for patients with advanced, progressive, SSTR-positive midgut NETs.
High‑Yield Points - ⚡ Biggest Takeaways
- Carcinoid syndrome presents with flushing, diarrhea, bronchospasm, and right-sided cardiac lesions.
- Diagnose carcinoid syndrome via elevated urinary 5-HIAA levels.
- Chromogranin A (CgA) is a sensitive tumor marker for most NETs.
- Somatostatin analogues (e.g., Octreotide) are key for managing symptomatic NETs.
- Pancreatic NETs (e.g., gastrinoma, insulinoma) are strongly associated with MEN 1 syndrome.
- Gastrinomas (ZES) cause refractory peptic ulcers and markedly high gastrin levels.
- Insulinomas characteristically manifest with fasting hypoglycemia and Whipple's triad.
Unlock the full lesson and continue reading
Signup to continue reading this lesson and unlimited access questions, flashcards, AI notes, and more